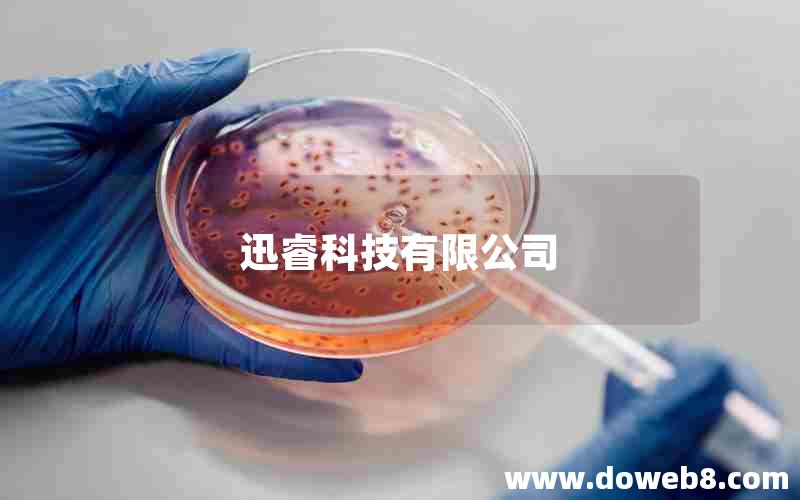
迅睿科技有限公司

迅睿cms本地部署教程:简单易懂的视频指导
迅睿cms是一款功能强大的内容管理系统,本文将为大家提供一份简单易懂的视频指导,帮助大家轻松完成迅睿cms的本地部署。无论你是初学者还是有一定经验的开发者,通过本文的指导,你都能够快速掌握迅睿cms的部署方法,为自己的网站搭建打下坚实的基础。无需担心繁琐的步骤,视频教程将为你一一解析,让你轻松上手。无论你是个人博客、企业网站还是电商平台,迅睿cms都能够满足你的需求。让我们一起来学习吧!
1、迅睿cms本地部署教程:简单易懂的视频指导

迅睿cms是一款功能强大的内容管理系统,为了方便用户使用,可以选择进行本地部署。本文将为大家介绍一份简单易懂的视频指导,帮助大家快速上手迅睿cms的本地部署。
我们需要准备一些必要的工具和环境。确保你的电脑已经安装了PHP环境和MySQL数据库。如果没有安装,可以通过搜索引擎找到相关的教程进行安装。
接下来,我们需要下载迅睿cms的安装包。你可以在官方网站上找到最新的版本,并下载到本地。下载完成后,解压缩安装包到你喜欢的目录下。
现在,打开你的MySQL数据库管理工具,创建一个新的数据库,并记住数据库的名称和登录信息,我们稍后会用到。
接下来,打开你的Web服务器,将迅睿cms安装包解压缩的文件夹放置在Web服务器的根目录下。确保你的Web服务器已经正确配置,并且能够访问到这个目录。
现在,打开你的浏览器,输入你的Web服务器的地址,如果一切正常,你应该能够看到迅睿cms的安装界面。
按照安装界面的提示,填写必要的信息,包括数据库的名称、登录信息等。确保你填写的信息是正确的,并且你的数据库已经正确创建。
点击安装按钮,迅睿cms将会自动进行安装。等待安装完成后,你将会看到一个成功安装的提示。
现在,你可以通过访问你的Web服务器的地址来访问迅睿cms的后台管理界面了。输入你在安装过程中设置的***账号和密码,登录到后台管理界面。
在后台管理界面,你可以进行各种设置和管理操作,包括创建和管理内容、设置网站的样式和布局等。
通过本地部署,你可以更加方便地进行迅睿cms的使用和管理。本文提供的视频指导将会帮助你快速上手,让你能够轻松地搭建和管理自己的网站。
总结一下,迅睿cms的本地部署并不复杂,只需要准备好必要的工具和环境,按照安装界面的提示进行操作即可。通过本地部署,你可以更加灵活地使用和管理迅睿cms,让你的网站更加个性化和专业化。希望本文提供的视频指导能够帮助到你,祝你在使用迅睿cms的过程中取得成功!
2、xunruicms本地部署教程:简单易懂的视频指导

迅睿cms是一款功能强大的内容管理系统,它可以帮助用户快速搭建自己的网站。本文将为大家介绍迅睿cms的本地部署教程,并提供简单易懂的视频指导。
我们需要准备一些工具和环境。我们需要安装一个本地服务器软件,比如XAMPP。XAMPP是一个集成了Apache服务器、MySQL数据库和PHP的开发环境,可以方便地搭建本地的网站。我们可以在官方网站上下载XAMPP,并按照提示进行安装。
安装完成后,我们需要下载迅睿cms的安装包。可以在迅睿cms官方网站上下载最新的安装包,并解压到XAMPP的网站根目录下,一般是在xampp/htdocs目录下。
接下来,我们需要创建一个数据库来存储网站的数据。打开浏览器,输入localhost/phpmyadmin,进入phpMyAdmin管理界面。在左侧导航栏中点击“新建”,输入数据库名称,并选择“utf8_general_ci”作为字符集和排序规则。点击“创建”按钮,即可成功创建一个数据库。
现在,我们可以开始安装迅睿cms了。在浏览器中输入localhost,即可访问XAMPP的默认页面。点击“迅睿cms安装”,进入安装向导界面。我们需要选择语言,这里选择简体中文。接下来,系统会检测服务器环境是否满足安装要求,如果有问题需要解决。然后,我们需要输入数据库的连接信息,包括数据库名称、用户名、密码和数据库主机。填写完毕后,点击“下一步”按钮。
在下一步中,我们需要设置网站的基本信息,包括网站名称、***账号和密码等。填写完毕后,点击“下一步”按钮。在接下来的步骤中,我们可以选择安装一些默认的模块和插件,也可以在后续进行安装。点击“下一步”按钮,系统将开始安装迅睿cms。
安装完成后,我们可以通过访问localhost来查看我们的网站了。可以在迅睿cms后台进行网站的配置和管理,比如更改主题、添加内容等。
为了帮助大家更好地理解迅睿cms的本地部署过程,我们还提供了一段简单易懂的视频指导。在视频中,我们将一步一步地演示如何安装XAMPP、下载迅睿cms、创建数据库以及进行安装配置。通过观看视频,大家可以更直观地了解整个过程,更快速地完成本地部署。
总结一下,迅睿cms的本地部署教程并不复杂,只需要准备好工具和环境,按照步骤进行操作即可。通过本地部署,我们可以更方便地进行网站的开发和测试,为用户提供更好的体验。希望本文和视频指导能够帮助大家顺利完成迅睿cms的本地部署,快速搭建自己的网站。
3、迅睿科技有限公司
迅睿科技有限公司是一家致力于科技创新的企业。公司成立于20XX年,总部位于中国的一个科技城市。自成立以来,迅睿科技一直以技术创新和产品质量为核心竞争力,迅速成为行业的领导者之一。
作为一家科技公司,迅睿科技注重研发和创新。公司拥有一支高素质的研发团队,他们不断追求技术突破和创新,致力于为客户提供更好的产品和解决方案。迅睿科技的产品涵盖了多个领域,包括人工智能、物联网、大数据等。这些产品不仅在国内市场上获得了广泛的应用,还在国际市场上赢得了良好的口碑。
迅睿科技一直坚持以客户为中心的理念。公司深入了解客户需求,不断改进产品和服务,以满足客户的不断变化的需求。迅睿科技的产品不仅具有高性能和稳定性,还注重用户体验,为用户提供便捷、高效的解决方案。公司建立了完善的售后服务体系,确保客户在使用过程中得到及时的支持和帮助。
除了技术和产品的创新,迅睿科技还注重企业文化的建设。公司倡导团队合作和员工发展,鼓励员工提出新的想法和创新,激励员工追求卓越。迅睿科技为员工提供良好的工作环境和发展机会,关注员工的职业发展和生活福利,努力营造积极向上的企业文化。
迅睿科技始终秉持诚信和负责任的原则。公司严格遵守法律法规,保护客户和合作伙伴的利益。迅睿科技重视知识产权保护,积极参与知识产权的申请和保护工作。公司与各级、高校和研究机构积极合作,共同推动科技创新和产业发展。
未来,迅睿科技将继续坚持科技创新,不断提升产品和服务质量,为客户提供更好的解决方案。公司将加强与国内外合作伙伴的合作,拓展国际市场,推动科技创新和产业升级。迅睿科技相信,通过不断努力和创新,将为社会和客户创造更大的价值。
迅睿科技,科技创新的引领者,为未来带来更多可能!
通过本文的视频指导,我们可以轻松地学习和实践迅睿cms的本地部署。视频教程以简单易懂的方式呈现,让我们可以快速上手。本地部署的好处是可以在本地环境进行开发和测试,提高工作效率。本地部署还能够保护数据的安全性,避免因网络原因导致的数据泄露风险。我们了解了迅睿cms的安装步骤、配置要点和常见问题解决方法,这些知识对于使用迅睿cms的用户来说非常有价值。希望本文能够帮助大家顺利完成迅睿cms的本地部署,为网站开发和管理提供便利。
2. 本站积分货币获取途径以及用途的解读,想在本站混的好,请务必认真阅读!
3. 本站强烈打击盗版/破解等有损他人权益和违法作为,请各位会员支持正版!
4. 建站教程 > 迅睿cms本地部署教程:简单易懂的视频指导


